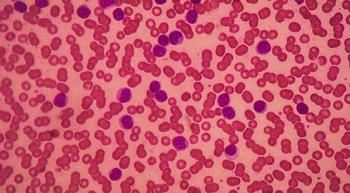

In the minds of Americans, there is no more trusted profession than nursing, according to a global analytics company called Gallup, which recently announced that for the 17th year in a row, nurses topped the list by a landslide.

In the minds of Americans, there is no more trusted profession than nursing, according to a global analytics company called Gallup, which recently announced that for the 17th year in a row, nurses topped the list by a landslide.

Julie Pederson, BSW, RN, OCN, CBCN, provides an overview of developments in research on lymphedema treatments.

Oncology nurses must not only be aware of the adverse events (AEs) of immunotherapy, but they must also educate their patients—and their other healthcare providers—to recognize them as well, according to Massey Nematollahi, MScN, RN, CNS, OCN, CON.

Because of the risk for developing secondary malignancies, and given the association between smoking and cancer, all patients who smoke should be counseled about quitting, according to Linda Sarna, PhD, RN, FAAN.

Although few statistics are available to assess how patients with cancer are affected by prescription opioid use, a recent study found that 70% of patients with cancer use opiates after radiation.

The Food and Drug Administration (FDA) expanded the approval of eltrombopag (Promacta) in combination with standard immunosuppressive therapy to include first-line use in newly diagnosed adult and pediatric patients aged 2 years and older with severe aplastic anemia.

The clinical trials program at the Lehigh Valley Cancer Institute grew exponentially in a short period of time. A great problem to have, certainly, but challenging to the organization.

Sexuality after cancer is an under-discussed topic between healthcare providers and patients, and nurses especially have an important role to play in raising the subject with patients, according to Anne Katz, PhD, RN, FAAN.

There is an increasing need for board-certified genetic counselors in the United States, says Stephanie A. Cohen, MS, LCGC, and she is looking to nurses to help improve patient access to hereditary cancer risk assessment and genetic testing.

After a computerized assessment, patients choose between traditional or virtual therapy.

A panel of experts gathered at a preconference presentation at the Association of Community Cancer Centers 35th National Oncology Conference in Phoenix to exchange their thoughts on the practical and theoretical considerations of incorporating biosimilars into the healthcare ecosystem.

Treatment for multiple myeloma is quickly evolving. To bring physicians, nurses, and other members of the community oncology care team up to date, Abhinav B. Chandra, MD, MSc, FACP, conducted a presentation at the Association of Community Cancer Centers (ACCC) 35th National Oncology Conference in Phoenix, Arizona.

At the Association of Community Cancer Centers (ACCC) 35th National Oncology Conference, Jessica Clague DeHart, PhD, MPH, discussed how clinicians can communicate the importance of physical activity and good nutrition practices to patients.

How can oncology teams become more resilient in the face of growing professional challenges?

To help patients and programs meet the challenges of affording cancer treatments, community cancer centers are expanding the role of financial advocates in their organizations. Financial advocates may be financial counselors, nurses, navigators, social workers; pharmacy technicians; practice managers, and others.

The Food and Drug Administration (FDA) approved Gardasil 9 (Human Papillomavirus 9-valent Vaccine, Recombinant) to expand its use in women and men aged 27 to 45 years.

The Better Business Bureau (BBB) is warning consumers to make informed decisions about donating to breast cancer charities that businesses claim to be supporting during Breast Cancer Awareness Month.

To determine what Americans know—and think they know—about prostate cancer, the PCF surveyed more than 2000 adults in the United States and uncovered some misperceptions that might prevent men who are at risk from accessing screening.

The Food and Drug Administration (FDA)’s recent crackdown on retailers and manufacturers who are marketing and selling e-cigarettes and e-cig products to youths was a step forward in the fight to prevent smoking in young people, says Linda Sarna, PhD, RN, FAAN.

The FDA launched a pilot program designed to advance innovative clinical trial designs.

The FDA has granted a priority review to the immunostimulatory monoclonal antibody elotuzumab (Empliciti) for use in combination with pomalidomide (Pomalyst) and low-dose dexamethasone (EPd) to treat patients with relapsed/refractory multiple myeloma (MM) who have received 2 or more prior therapies, including lenalidomide (Revlimid) and a proteasome inhibitor.

Distinguished nurse scientist, professor, and associate dean of research and scholarship leaves a lasting legacy.

New York City agreed to pay a $20.8 million settlement for its nurses and midwives who filed federal discrimination charges against the Justice Department, claiming it did not recognize their work as “physically taxing” compared with City employees who were predominantly male in physically demanding roles.

If the Senate’s version of the Department of Defense Appropriations Act, 2019 is signed into law, young adults could lose millions of dollars of support for AYA-specific research.

The FDA granted a priority review to a new drug application for glasdegib, an investigational oral smoothened inhibitor, for the treatment of adult patients with previously untreated acute myeloid leukemia in combination with low-dose cytarabine, a type of chemotherapy.

A foundational volume in oncology nursing gets an upgrade.
A multidisciplinary team approach may help in seeing optimal patient outcomes following the administration of a powerful drug combination for patients with relapsed/refractory chronic lymphocytic leukemia (CLL).

Ribociclib (Kisqali), a targeted CDK4/6 inhibitor, is gaining traction in the treatment of hormone receptor–positive, human epidermal growth factor receptor (HER) 2–negative advanced breast cancer, and nurses and patients need to be educated about its possible adverse effects (AEs).

CancerCare study is part of greater initiative aimed at ensuring that patient engagement in decision making becomes part of the standard of care.

On April 25-26, almost 2000 nurses will descend on Washington DC to fight for legislation that would establish fair nurse-to-patient ratios.

July 31st 2017

September 12th 2017

November 8th 2017

November 8th 2017